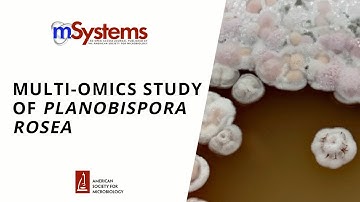
Multi-omics Study of Planobispora rosea

⬇ DOWNLOAD NOW
Kalau muncul iklan pop-up, tutup lalu klik tombol kembali
Download lagu What are Multi-omics? secara gratis hanya untuk keperluan promosi. Dukung artis favorit kamu dengan membeli musik original di iTunes atau platform resmi lainnya.
 Intro to Multiomics
Intro to Multiomics
 The Future of Multi-Omics: Integrating Genomics, Proteomics, and Transcriptomics
The Future of Multi-Omics: Integrating Genomics, Proteomics, and Transcriptomics
 Multi-Omics: The Future of Personalized Medicine
Multi-Omics: The Future of Personalized Medicine
 Multiomics is changing the game - hear from researchers using it
Multiomics is changing the game - hear from researchers using it
 What is Multi-omics?
What is Multi-omics?
 Multi-Omics : The Biological Revolution. #multiomics
Multi-Omics : The Biological Revolution. #multiomics
 What Is Multi-omics Spatial Transcriptomics? - Oncology Support Network
What Is Multi-omics Spatial Transcriptomics? - Oncology Support Network
Multi-omics Study of Planobispora rosea
Multi-omics Study of Planobispora rosea